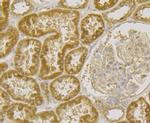
RNASE3 Antibody in Immunohistochemistry (Paraffin) (IHC (P))

Search
Invitrogen
RNASE3 Monoclonal Antibody (5G4)
{{$productOrderCtrl.translations['antibody.pdp.commerceCard.promotion.promotions']}}
{{$productOrderCtrl.translations['antibody.pdp.commerceCard.promotion.viewpromo']}}
{{$productOrderCtrl.translations['antibody.pdp.commerceCard.promotion.promocode']}}: {{promo.promoCode}} {{promo.promoTitle}} {{promo.promoDescription}}. {{$productOrderCtrl.translations['antibody.pdp.commerceCard.promotion.learnmore']}}
图: 1 / 6
RNASE3 Antibody (MA5-34931) in ICC/IF

产品信息
MA5-34931
种属反应
宿主/亚型
分类
类型
克隆号
抗原
偶联物
形式
浓度
规格
纯化类型
保存液
内含物
保存条件
运输条件
RRID
产品详细信息
Positive Control: U937, Hela, SHG-44, human spleen tissue, human kidney tissue.
靶标信息
ECP (eosinophil cationic protein), also known as RNS3 or RNASE3 (ribonuclease, RNase A family, 3), is a 160 amino acid potent cytotoxic secretory protein that belongs to the pancreatic ribonuclease family. ECP localizes to the granule matrix of the eosinophil and is involved in the immune response system. ECP is a cytotoxin, neurotoxin and helminthotoxin that is secreted by activated human eosinophils. ECP exhibits anti-parasitic, antibacterial and ribonucleolytic activities. It has been suggested that ECP induces the neurotoxic effect known as the Gordon phenomenon, a syndrome manifested by ataxia, muscular rigidity, paralysis and tremor that may lead to death. ECP is considered a marker of eosinophilic inflammation and high levels have been found in cases of active asthma and other allergic diseases.
仅用于科研。不用于诊断过程。未经明确授权不得转售。
篇参考文献 (0)
生物信息学
蛋白别名: cytotoxic ribonuclease; ECP; Eosinophil cationic protein; Ribonuclease 3; ribonuclease, RNase A family, 3; RNase 3; unnamed protein product
基因别名: ECP; RAF1; RNASE3; RNS3
UniProt ID: (Human) P12724
Entrez Gene ID: (Human) 6037




